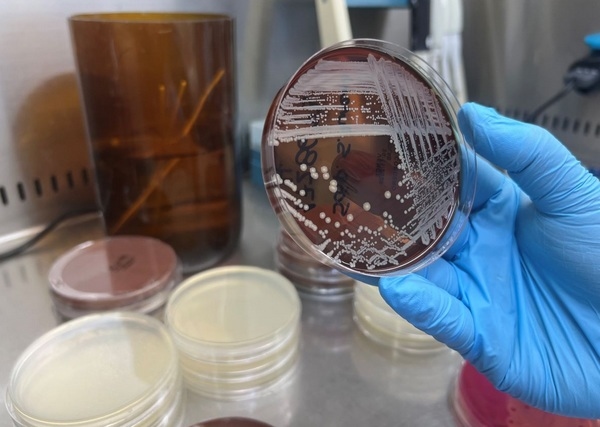
Chile - Laboratorio de Patología Aviaria en la Universidad de Chile: más de seis décadas de servicio - Image 1

Desde su creación en 1960, el Laboratorio de Patología Aviaria de la Facultad de Ciencias Veterinarias y Pecuarias (Favet) de la Universidad de Chile se ha consolidado como un referente nacional en docencia, investigación y diagnóstico en el ámbito de la medicina veterinaria y la producción avícola.
En 2008 el equipo amplió su campo de acción incorporando servicios de diagnóstico y análisis dirigidos a terceros, lo que permitió estrechar el vínculo entre la academia y el sector productivo
Fundado con la misión inicial de apoyar la formación de pre y postgrado en Medicina Veterinaria, el Laboratorio de Patología Aviaria (LPA) ha contribuido por más de sesenta años a la generación de conocimiento científico y al fortalecimiento de la salud aviar en el país. Durante sus primeras décadas, su labor se centró en la enseñanza universitaria y la investigación aplicada; sin embargo, en 2008 el equipo amplió su campo de acción incorporando servicios de diagnóstico y análisis dirigidos a terceros, lo que permitió estrechar el vínculo entre la academia y el sector productivo.
“Hay una necesidad constante del sector productivo nacional en temas de sanidad avícola; el laboratorio entrega valiosos resultados a través de diferentes técnicas diagnósticas y también apoya la realización de ensayos y capacitaciones. Por otra parte, están los proyectos de investigación en lo que el laboratorio puede ser el ejecutor o colaborador, y de esta forma se da respuesta a un vacío en el conocimiento científico que posteriormente es traspasable a la industria avícola”, puntualiza el Dr. Miguel Guzmán, académico de Favet y actual director del LPA.
Dr. Miguel Guzmán, director del Laboratorio de Patología Aviaria de Favet.
El Dr. Guzmán se incorporó a Favet durante el año 2024 como académico del Departamento de Patología Animal y ahora asumió la dirección del Laboratorio de Patología Aviaria, tras la jubilación del Dr. Héctor Hidalgo. En este contexto, impulsó la creación del Diplomado en Producción y Patología Avícola. “Se trata de un postítulo único que se oferta en el mercado, y que viene a dar respuesta a una necesidad de perfeccionamiento por parte de los colegas del área que no estaba siendo cubierta”, acotó el especialista.
Actualmente, el LPA ofrece una amplia gama de servicios especializados, entre los que destacan: diagnóstico post mortem y necropsia, bacteriología, virología, serología (ELISA), biología molecular (PCR), ensayos nutricionales, productivos y sanitarios, además de investigación, desarrollo y validación de productos avícolas. El equipo también realiza capacitaciones técnicas y actividades de transferencia de conocimiento, reafirmando su compromiso con la formación continua y actualización del sector.
El laboratorio cuenta con acreditación bajo la Norma NCh-ISO 17025.Of2017, que certifica la calidad y competencia técnica de sus ensayos. Entre ellos se encuentra la detección de Salmonella spp. en aves, ambiente y alimentos. Asimismo, el LPA es una unidad externa autorizada por el Servicio Agrícola y Ganadero (SAG) para la aplicación de técnicas de ELISA en el diagnóstico de Influenza Aviar, y en la detección de Mycoplasma gallisepticum, Mycoplasma synoviae y Mycoplasma meleagridis —requisito esencial para la certificación de reproductoras libres de Mycoplasma spp.
En situaciones de emergencia sanitaria, como los brotes de Influenza Aviar registrados en el país, el LPA ha cumplido un rol clave de apoyo técnico al SAG, participando en muestreos serológicos de perifocos y contribuyendo activamente al control y vigilancia epidemiológica a nivel nacional.
Bajo la dirección del Dr. Guzmán, el laboratorio atraviesa actualmente un proceso de modernización tecnológica. Uno de los principales avances ha sido la transición desde técnicas de PCR convencional hacia metodologías de qPCR, lo que mejora la rapidez, sensibilidad y precisión de los diagnósticos, fortaleciendo así la capacidad de respuesta ante los desafíos actuales de la industria avícola.
“En el contexto de la producción avícola nacional, se necesita de respuestas rápidas y confiables, es por esto que estamos avanzando hacia un laboratorio más moderno, ágil y conectado con las demandas del país. La innovación en el diagnóstico de patologías es clave para dar este tipo de respuesta frente a escenarios cambiantes, y, con esto, poder proteger la sanidad aviar y fortalecer la seguridad alimentaria en Chile”, afirma el Dr. Guzmán, destacando especialmente el esfuerzo que se está llevando a cabo para autorizar al LPA para procesar muestras oficiales provenientes del sistema de autocontrol obligatorio (SAO) de salmonella spp. en la cadena de producción de carne de aves.
El Laboratorio de Patología Aviaria de Favet mantiene una estrecha relación con la docencia de pre y postgrado, la investigación aplicada y la colaboración con instituciones públicas y privadas. De esta manera, se consolida como un centro integral de referencia en salud aviar, comprometido con la formación de profesionales, el desarrollo sostenible de la avicultura chilena y la protección de la salud pública.
El Laboratorio de Patología Aviaria cuenta con acreditación bajo la Norma NCh-ISO 17025.Of2017, que certifica la calidad y competencia técnica de sus ensayos.